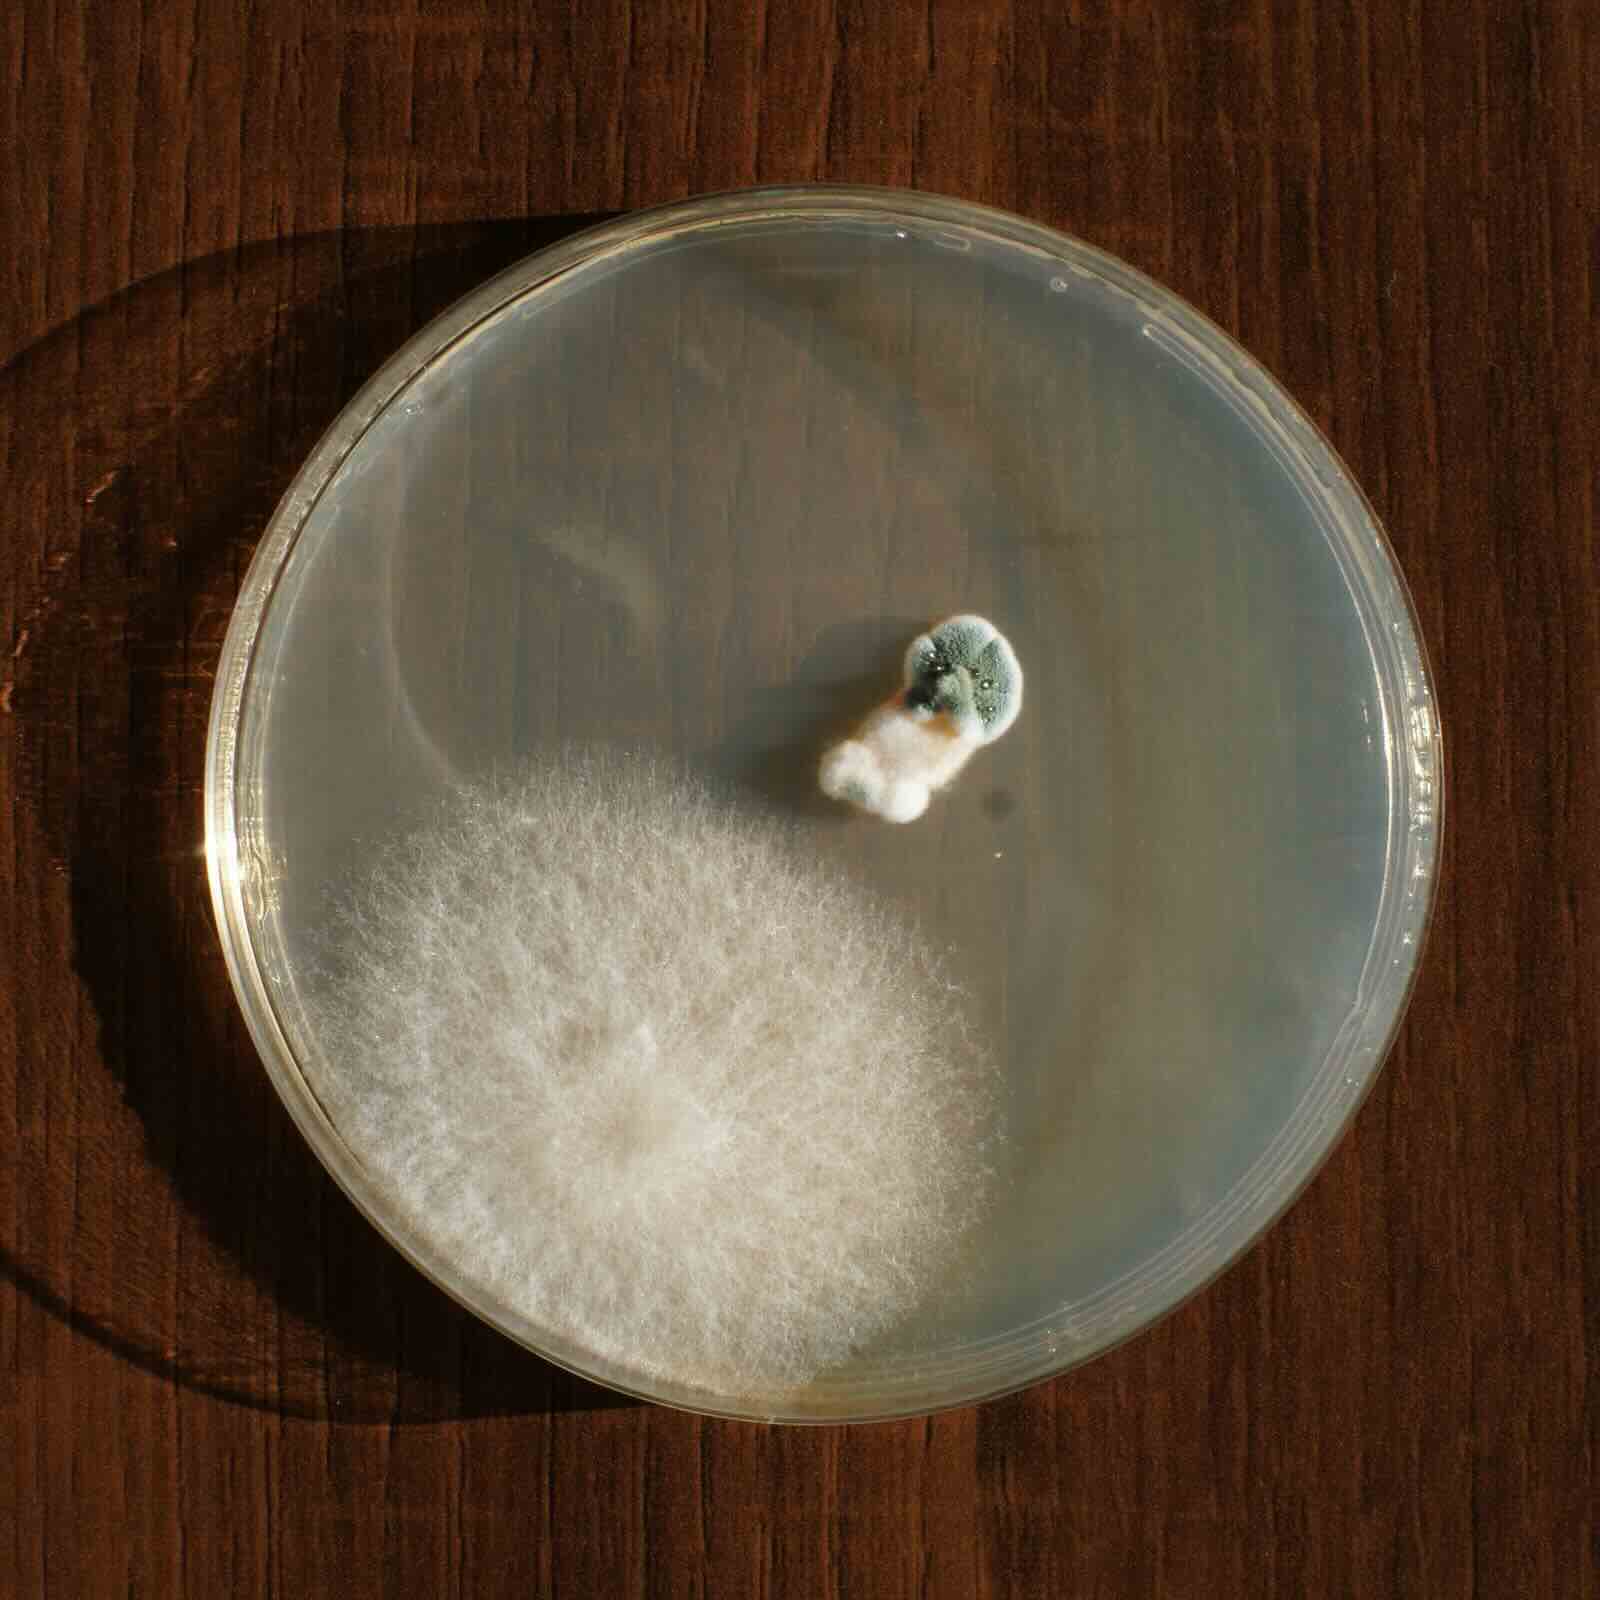

7. BioFabricating Materials¶
BioFabricating Materials¶
Bio-plate, Photo by Erika Mirzoyan
Research¶
Biomaterial is a completely new area of research for me. The first time I came across biomaterials, where I could actually touch and smell one, was upon my visit to Fab Lab Dilijan. Erika Mirzoyan had been experimenting with different recipes and she had very impressive results using clay powder. A few days after the visit, I stumbled upon a youtube video of the Fabricademy in Barcelona called Grow your clothes: grass dress, algae shoes, kombucha fabric and honestly I was hooked. It felt like the continuation of biochromes. I wouldn't say the next step, but I would say the step that could go parallel to natural dyes. When joining Fabricademy, biomaterials week was one that I was looking forward to and here we are!
What a pleasure to start the week by listening to the lecture by Cecilia Raspanti, where she dissects a whole world of biofabrication of materials.
So, what are biomaterials?
In short they are a sustainable replacement to unsustainable materials (such as plastic), usually derived from natural, organic ingredients, that are compostable, biodegradable and all in all not harmful to the planet or to us! In our fast consuming frenzy, plastic waste is piling up, polluting even the most remote places on the planet. Yet somehow, the world is producing more and more plastic each year. Alongside this, there is of course the production of more sustainable materials. Bioplastics made out of corn, for example, look and feel just like the plastic we have grown to know and use, with a compostable stamp on it too. And this sounds wonderful right? However, it’s a little more complicated than that. A lot of ‘sustainable’ materials that are produced and are ‘compostable’ or ‘biodegradable’ need specific environments and conditions to actually decompose or biodegrade. They end up in trash, like the rest of the plastic and do not biodegrade or decompose.
Here is a short video from Precious Plastic that explains and experiments with a few 'sustainable' materials.
Fabricademy Alumni inspirations
References & Inspiratio¶
With discovering and actually getting some experience in creating biomaterials this week, a whole new world of science and craft has opened up! There are many researchers, artists and makers who have inspired me and a week feels too short to dedicate to biofabricating materials (especially since growing or drying some recipes does take a long time).
Lionne Van Deursen¶
Lionne Van Deursen’s work grabbed my eye from the lecture by Cecilia Raspanti, primarily because of her choice of colors and the fact that she works with Symbiotic Culture of Bacteria and Yeast (scoby). Working with scoby initially didn’t feel comfortable for me, due to its texture and smell (it reminded me of meat and I am a vegetarian), however after washing and handling it in the lab this changed. I am looking forward to seeing how our lab grown scoby leather will turn out. Lionne Van Deursen does this so delicately, the bio-leather created in her studio looks intricate and refined, yet durable. On top of it, she covers the full circle of sustainability, aiming to have minimal waste in her design and material growth. I also love that she only uses natural dyes, this is where I feel that biofabrication of materials can be a beautiful parallel to the process of natural dyeing.
![]() |
![]() |
|---|---|
| Lionne Van deursen, Process | Lionne Van deursen,Unfold |
![]() |
![]() |
|---|---|
| Lionne Van deursen, Biotic | Lionne Van deursen, Process |
Peelsphere¶
The company Peelsphere focuses mainly on producing sustainable biomaterial from fruit peels. They have made a closed-loop system and give great attention to sustainability, aesthetic, versatility and performance in their production. The process looks simple, the result delicate and aesthetically magnetic. Peelsphere also uses laser-cutting to produce their final designs, yet you can also weave, sew and embroider with it. They use natural dyes and the product is biodegradable.
![]() |
![]() |
|---|---|
![]() |
![]() |
|---|---|
Herbier Project¶
Paula Cermeño León’s Herbier Project has become an obsession. Beauty products in terms of their ingredients and their packaging is an area that I’ve been battling with for years. When you have sensitive skin, you are constantly looking for ways to improve it. I pay so much attention to the ingredients of the products I use, making sure that there is no green-washing. I also aim to buy products that use sustainable packaging, such as glass bottles which I can then re-use or re-fill. In this project Paula Cermeño León uses plant fibers and infuses them with plant based formulations. Nature holds the remedies we need to live a healthy and sustainable life and this project is a reflection of how that can be. How well it does its job is a different story. However, it is a great inspiration!
![]() |
![]() |
|---|---|
![]() |
![]() |
|---|---|
Process and workflow¶
Photos by Svetlana Khachatryan
Growing biomaterials loves and needs a clean environment. Setting up the studio, cleaning all the tools to make sure that all the wrok you do will not mold and be thrown out is extremely important. So, first step is bringing all the tools you need and setting them up before starting.
Tools¶
- Kitchen scales
- Rubber gloves
- Stainless steel whisk
- Wooden spoons
- Deep Trays
- Kitchen thermometer
- Measuring jars
- Stainless steel pots
- Molds, frames, non sticky materials
- Surface cleaning cloth or wipes
- Rubbing alcohol and vinegar solution for cleaning surfaces
Ingredients & Recipes¶
Growing Kombucha Leather¶
Note: Work in a clean and sterile environment not to introduce bacterias.
Beer
Ingredients
500 ml water
500 ml beer
100 gr sugar
20 ml vinegar
healthy scoby
Mix water, beer and sugar. Put it on low heat and stir so the sugar dissolves completely. Let it cool down a little, then add vinegar to bring pH to 3-4. Note: vinegar is added to create an environment that doesn’t allow mold to develop. Let the solution cool down. If there is beear foam on the top, remove it with a clean paper towl. Easiest way to do it is to glide the paper towel over the surface to collect the foam. When the solution cools down to 21-24C, add healthy clean scoby. Cover with a breathable natural clean fabric and put it in a dark room. Optimal temperature to grow kombucha leather is 24C.
Photos by Svetlana Khachatryan
Prepare this recipe by collecting the ingredients necessary, to be found in the list below:
Tea
Ingredients
1 L water
100 gr sugar
20 ml vinegar
30 gr of Black Tea
15 gr of Hibiscus Tea (for colour)
healthy scoby
Mix loose tea in hot water and let it sit for about an hour. Once the tea is ready, strain it to mke sure you do not have any loose tea and mix it with hot water (1L in total). Add the sugar and stir until all the sugar dissolves.
Photos by Svetlana Khachatryan
Let it cool a little and add the vinegar. Note: vinegar is added to create an environment that doesn’t allow mold to develop.
Photos by Svetlana Khachatryan
When the solution cools down to 21-24C, add healthy clean scoby. Cover with a breathable natural clean fabric and put it in a dark room. Optimal temperature to grow kombucha leather is 24C.
Photos by Svetlana Khachatryan
Check back in about a week to 10 days to feed it sugar so that it keeps growing! If mold has developed, throw it out and start over
How to clean scoby- Must put it in a soda ash solution. Let it sit for a while then wash under running water. Make sure the water is not warm. If there are black or yellow patches, you can remove with a clean knife
UPDATE
A week later we checked on our scoby bioleather and unfortunately the tea recipe was covered in mold. Sad to say goodbye. Another week later we checked on the beer recipe and that too had molded. It was interesting to observe the leather-like surfaces they had both developed, despite the mold. However, it was even more interesting to see how the beer recipe hadn't developed in the same way. There were just chunks of scoby-leather like material floating everywhere. I do hope you, dear reader, are not reading this while eating!
Scoby biocomposite - experiment¶
Ingredients
750 ml water
720 gr scoby
Dash of vinegar
12 gr alginate
80 gr glycerine
10 g calcium chloride
1 L water
Tools
Electric blender
Measuring cups
Scales
Wooden Spatula
Frame
Dough Scraper (or a flat spatula for spreading)
Spraying bottle
Use an electric blender to blend scoby and water.
Photos by Svetlana Khachatryan
Add a dash of vinegar, weigh and slowly introduce alginate.
Photos by Svetlana Khachatryan
Add the glycerine. Blend until the mix is one consistency and there are no lumps. You can add colorant as an option.
Mix 10g calcium chloride with 1L of water. Spray calcium chloride solution on a non sticky material with a frame around it. Spread the scoby mix evenly and let it dry slowly.
Photos by Svetlana Khachatryan
I checked back on the scoby biocomposite on day 3. It hadn't fully dried yet, however it has formed a texture that feels like skin. It is shrinking in size as its dehydrating.
Result
Basic Biomaterial Recipe¶
I was happy to start the process of biofabricating materials with this recipe. It isn't very experimental, yet its a wonderful way to be introduced to the process.
Ingredients
120 ml water
24 gr gelatine
12 gr glycerine
Optional
10 gr clay powder
2 drops of soap
Bed of wool
- Add water and gelatine to the pot and put on low heat and stir constantly.
- Raise temperature to max 80C, then leave to steep and cool to 50C-60C.
- Add glycerine and continue to stir.
- Prepare your frame with faux leather and a bed of wool.
- Pour the liquid over it while warm.
- Let it cool and dry for about 12 hours on a flat surface.
- Hang to airdry for another 12-24 hours.
![]() |
![]() |
|---|---|
| Photos by Svetlana Khachatryan |
Result
For better results, re-melt the biomaterial over low heat with a dash of water and redo the pour. This will yield more even results. If it feels too stiff you can add 5g of glycerine. If you have cut out and used the biomaterial and there are leftover scraps, you can also re-melt and re-use
![]() |
![]() |
|---|---|
| Photos by Svetlana Khachatryan |
Result
Photos by Svetlana Khachatryan
Agar-agar Corn Starch Bio-Leather¶
Ingredients
240 ml water
1 tbsp corn starch
1 tblsp gelatine
½ tsp agar agar
1 tbsp glycerine
1 tsp vinegar
- In a small pot mix the dry materials together - corn starch, gelatine, agar-agar.
- Add 1 cup cold water and mix well. Cook on low heat and mix continuously. Once you start feeling slight resistance when stirring, add the glycerine and vinegar and continue to stir.
Photos by Svetlana Khachatryan
Optional : Add a pinch or 1/2tsp of cinnamon and dried flower petals.
Note: Why I chose to add cinnamon is because it has natural antibacterial property and agar agar biomaterials tend to mold easily. Vinegar is also added for this reason, but I thought it won’t hurt if I add an extra layer of antibacterial property!
Photos by Svetlana Khachatryan
- Pour onto a non-stick material like a silicon mat or faux leather with a frame.
I also added a little bit of wool on the bed before pouring the liquid over it. - Spread evenly and let it air dry for 12h, then remove from the frame (if it's not too wet still).
When it comes to how fast it dries (or grows in other recipes) the environment matters a lot - the level of humidity, the temperature in the room etc. In Dilijan, we were able to remove it from the frame within 12h. It had not fully dried yet, but that’s the point. I wanted to give this sheet a little bit of form. After removing it, I oiled the outside bottom of a small stainless steel dish with some olive oil and placed the sheet of agar-agar leather on top. Carefully pressing the edges to envelope the plate, I put it in front of a tiny fan and left it there for another 12h to air dry. I used the electric fan, because it is humid in Dilijan and the room didn’t have a lot of air flow.
Result
Bio-plate, Photo by Erika Mirzoyan
By the time it was time to remove from the stainless steel form, I was no longer in the lab. However, I kindly asked Anoush Arshakyan to desbribe to me how it felt, smelled etc. She described how it smells like cinnamon of course! It's a little elastic, but it hasn't fully dried yet. It has an interesting texture thanks to the wool, it has become a lot thinner (as expected). It still needs time to fully dry. I love that it's translucent and has an organic shape. I hope that we can use it in the lab to put some dried fruits and nuts and at some point maybe even dig a hole in the garden and put it there to see how long it takes for it to decompose. I imagine not too long!
Alginate Yarn¶
Ingredients
400 ml water
8 gr alginate
25 gr glycerine
1 L water
10 g Calcium Chloride
Make a 10% calcium chloride solution by mixing calcium chloride with water and put aside.
- Add water and 8g of alginate and mix well. Alginate will make lumps, but this is okay. You can mix, let it sit for a minute, and mix again over and over. Don’t overmix for too long as it will stiffen the alginate.
- Add the glycerine and mix well to make a uniform body of material.
Photos by Svetlana Khachatryan
Note: We wanted to add some natural pigment to our alginate yarn, so we added a few drops of Saffron wastewater pigment that Fatmeh Mollaie had made during Fabricademy in 2025. As soon as we added the liquid pigment, the alginate mix started to stiffen and act like it would if you place it in calcium chloride. Thankfully we hadn’t added too much and were able to remove the parts that changed form. I checked her recipe and she has used citric acid or vinegar to produce the liquid pigment. I researched further and found out that citric acid or vinegar, because of their low pH, act like calcium chloride does when introduced to alginate, making it form into a gel like/ opaque material.
- Once the alginate mix is ready, use a large syringe to suck the alginate.
- Slowly push the alginate into the calcium chloride solution to produce yarn like shape.
- Let it sit for a few minutes. At this point it will be a gel-like material.
- Wash it under cool running tap water and place it on a tray to dry.
Photos by Svetlana Khachatryan
Expectation- alginate shrinks a lot when dries, so the thick gel-like yarn will become thinner.
Alginate Yarn right after preparing, Photo by Svetlana Khachatryan
![]() |
![]() |
|---|---|
Alginate Yarn after 24h, Photo by Svetlana Khachatryan
Basic Biomaterial Recipe with additions¶
I was happy with the results of this recipe with the addition of clay powder, soap drops and a bed of wool, so I decided to repeat again but change it around a little.
Ingredients
120 ml water
24 gr gelatine
12 gr glycerine
Add-ons
10 gr quartz sand
4 drops of soap
10 gr clay
- Add water and gelatine to the pot and put on low heat and stir constantly.
- Raise temperature to max 80C, then leave to steep and cool to 50C-60C.
- Add glycerine and continue to stir.
- Add clay and soap and sitr.
- Prepare your frame with faux leather.
- Pour the liquid in the frame and sprinkle the quartz sand.
- Let it cool and dry for about 12 hours on a flat surface.
- Hang to airdry for another 12-24 hours.
![]() |
![]() |
|---|---|
| Photos by Erika Mirzoyan |
Trials and Errors¶
Agar-agar recipe¶
As the initial Agar-agar recipe was a success, I decided to experiment a little further. I repeated the same recipe but this time I used leftover tea dye bath instead of water and added a teaspoon of clay powder to the mix.
Photos by Svetlana Khachatryan
I was aiming to have a slightly harder, earthier material, which I would mold into another bowl after the initial dehydration. However, this time it stuck to the faux leather.
Photos by Svetlana Khachatryan
This could be due to a thick layer of pour, or maybe it was the addition of the clay, or the fact that I didn't add wool on the bed, it had too much grip.
I had also poured some on a silicon matt.
Photos by Svetlana Khachatryan
I decided to repeat the recipe again, adding only 1/2 teaspoon of clay powder and using rice vinegar instead of regular. I also had a lot of cutch dye, so I used that instead of water to give it a lovely color.I also oiled the bed slightly. This stuck even more. It has been over 48h and it is still wet. Maybe it's the amount of glycerin? Or mayve the tannins in my dye bath? Although I would think that the tannins would help sticking everything together, not everything to the bed..It could also be that I am rushing. At this point, I will leave it for another day and hope that I can scrape it off.
Photos by Svetlana Khachatryan
After another 24h, I managed to peel off the very shrunken bio-platic, not very smoothly as you can see. It's a lot stiffer than I expected it to be, it would work perfectly with a mold to give it shape.
Photos by Svetlana Khachatryan
Let's just say that I don't give up so easily, so I went back to the recipe and tried it again. This time I didn't add any clay. I want to figure out what it is that makes it so 'sticky' and takes forever to dry. Instead I used the cutch leftover dye bath again instead of water and added a bit of red onion skins on the bed. I had made a red onion skin dye bath, and I didn't want to compost the skins just yet. I also poured this one on a silicon sheet and made a thinner layer. After about 72h, the sheet peeled off smoothly. I'm in love! It's elastic, smells delicious (cinammon). I would wrap my sandwich in it.
Photos by Svetlana Khachatryan
Conclusion
I would like to try again, but add half the glycerin I have been adding, make a thin layer pour (even though it already shrinks in size) and leave it to dry for at least 72h before attempting to peel.
Documenting and comparing experiments¶
TEST SERIE BIO-PLASTIC¶
Mycelium¶
On one of the days during this week, after a rainy night, we went for a hike in the mountains in search of mushrooms. We came across about 5-6 types. I decided to use them to make both natural dyes and try and attempt growing mycelium. I am sure that it will mold, but I will try and try again to make it work eventually.
![]() |
![]() |
![]() |
|---|---|---|
![]() |
![]() |
![]() |
The most important thing to do is to sanitize everything before starting. I sanitized everything with rubbing alcohol, including my hands, the table, the glass jars.. Everything!!
This is of course a complete experiment, but I decided to use agar as the food source. In one of the jars I also added (pre boiled) organic hemp fabric. In another jar I added wool fabric and cotton fabric dyed with madder and cutch (both boiled for a minimum of 30 minutes). In a third jar, I only added the agar mix and sanitised it by boiling the jar in a pot of water as I don’t have a pressure cooker.
![]() |
![]() |
![]() |
|---|---|---|
| agar solution and mushroom cutouts | agar solution and madder dyed fibre | Agar solution and organic hemp fibre |
After a week..
![]() |
![]() |
|---|---|
| Photos by Svetlana Khachatryan |
Another try and another fail..
It's safe to say that I failed at growing mycelium.. for now.
I will also leave this video here for you to watch later!